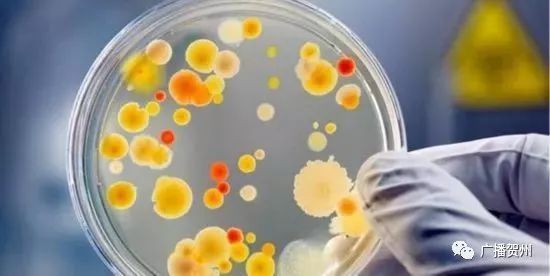
广西最近公布14批次不合格食品,广西公布12批次不合格食品

←
糕点、饮用水

监督抽检
近期,广西壮族自治区食品药品监督管理局组织抽检粮食加工品、饮料、糕点等3类食品219批次样品,抽样检验项目合格样品201批次,不合格样品18批次。根据食品安全国家标准,个别项目不合格,该样品即判定为不合格产品。具体情况公告如下:
一、抽检总体情况
所有抽检样品遵循随机抽样原则。抽检粮食加工品样品32批次,不合格样品1批次;抽检饮料样品70批次,不合格样品10批次;抽检糕点样品117批次,不合格样品7批次。
二、不合格样品产品情况
(一)全州县味美佳食品厂销售的标称“全州县味美佳食品厂”生产的“干制米粉”样品(商标:/,生产日期/批号:2018-08-04,规格:计量称重/20kg),脱氢乙酸及其钠盐(以脱氢乙酸计)检出值为0.275g/kg,标准规定不得检出。检验机构为广西壮族自治区产品质量检验研究院。
(二)*白县博**城区小高副食店销售的标称“北海市凉源纯净水有限公司”生产的“饮用纯净水”样品(商标:凉源,生产日期/批号:2018-04-16,规格:580ml/瓶),铜绿假单胞菌检出值为①9CFU/250mL、②<1CFU/250mL、③<1CFU/250mL、④<1CFU/250mL、⑤<1CFU/250mL,标准规定检出值为n=5,c=0,m=0CFU/250mL。检验机构为广西-东盟食品药品安全检验检测中心。
(三)广西龙州康宝益大圆保健品有限公司销售的标称“广西龙州康宝益大圆保健品有限公司”生产的“蝮蛇薏苡仁颗粒”样品(商标:豪刚,生产日期/批号:2018-02-06,规格:36克(3克×12袋/盒)),铅(以Pb计)检出值为2.33mg/kg,标准规定检出值为≤1.0mg/kg;标称“广西龙州康宝益大圆保健品有限公司”生产的“黄精山药颗粒”样品(商标:豪刚,生产日期/批号:2018-02-03,规格:24克(2克×12袋/盒)),铅(以Pb计)检出值为1.61mg/kg,标准规定检出值为≤1.0mg/kg。检验机构为广西-东盟食品药品安全检验检测中心。
(四)南宁市星羽水屋销售的标称“广西蒙山县玉梦山矿泉水有限公司”生产的“玉梦山优质饮用山泉水”样品(商标:玉梦山(艺术字)及图形商标,生产日期/批号:2018-07-05,规格:18L/桶),溴酸盐检出值为0.014mg/L,标准规定检出值为≤0.01mg/L。初检机构为广西-东盟食品药品安全检验检测中心,复检机构为广西壮族自治区产品质量检验研究院。
(五)广西利客隆超市有限公司南宁友爱店销售的标称“广西木论天然食品有限公司”生产的“木论思泉(包装饮用水)”样品(商标:/,生产日期/批号:2017-01-02,规格:469ml/瓶),溴酸盐检出值为0.013mg/L,标准规定检出值为≤0.01mg/L。初检机构为广西-东盟食品药品安全检验检测中心,复检机构为广西壮族自治区产品质量检验研究院。
(六)南宁市靖之水饮用水经营部销售的标称“广西南宁市添宝饮品制造有限责任公司”生产的“石埠山泉饮用天然泉水”样品(商标:/,生产日期/批号:2018-07-11,规格:18L),铜绿假单胞菌检出值为①82CFU/250mL、②56CFU/250mL、③<1CFU/250mL、④2.8×104CFU/250mL、⑤<1CFU/250mL,标准规定检出值为n=5,c=0,m=0CFU/250mL。检验机构为广西-东盟食品药品安全检验检测中心。
(七)广西藤县绿色田园葛业有限公司销售的标称“广西藤县绿色田园葛业有限公司”生产的“葛根粉”样品(商标:/,生产日期/批号:2018-05-25,规格:200克(20克×10小包)/盒),菌落总数检出值为①1.1×104CFU/g、②1.3×104CFU/g、③1.1×104CFU/g、④1.2×104CFU/g、⑤1.1×104CFU/g,标准规定检出值为n=5,c=2,m=103CFU/g,M=5×104CFU/g。检验机构为广西-东盟食品药品安全检验检测中心。
(八)南宁市水碧清商贸有限公司销售的标称“广西贵港市花果山贸易有限公司”生产的“矿泉水”样品(商标:/,生产日期/批号:2018-07-26,规格:18升/桶),铜绿假单胞菌检出值为2.8×102CFU/250mL,标准规定检出值为第一次 0CFU/250mL,第二次n=4、c=1、m=0CFU/250mL、M=2CFU/250mL。检验机构为广西-东盟食品药品安全检验检测中心。
(九)桂平市圣藤康保健凉茶厂销售的标称“桂平市圣藤康保健凉茶厂”生产的“清热下火王低糖固体饮料”样品(商标:圣藤康及图形商标,生产日期/批号:2018-05-17,规格:160克(10克×16小袋)/袋),霉菌检出值为1.2×103CFU/g,标准规定检出值为≤50CFU/g。检验机构为广西-东盟食品药品安全检验检测中心。
(十)南宁市尚源桶装水店销售的标称“上林县自来水有限责任公司”生产的“明山泉包装饮用水”样品(商标:明山泉,生产日期/批号:2018-07-11,规格:18.9升/桶),铜绿假单胞菌检出值为①<1CFU/250mL、②3CFU/250mL、③<1CFU/250mL、④<1CFU/250mL、⑤<1CFU/250mL,标准规定检出值为n=5,c=0,m=0CFU/250mL。检验机构为广西-东盟食品药品安全检验检测中心。
(十一)*白县博**城区景乐超市销售的标称“*白县博**明亭食品厂”生产的“车轮汉堡(夹心酥皮面包)”样品(商标:/,生产日期/批号:2018-06-09,规格:净含量:90克),糖精钠(以糖精计)检出值为0.0711g/kg,标准规定不得使用。检验机构为梧州市食品药品检验所。
(十二)凤山县丰泽副食品店销售的标称“金城江区源味食品厂”生产的“面包(烘烤类糕点)”样品(商标:/,生产日期/批号:2018-08-17,规格:50克/袋),纳他霉素检出值为12.2mg/kg,标准规定不得使用;标称“金城江区源味食品厂”生产的“菠萝面包”样品(商标:/,生产日期/批号:2018-08-16,规格:85克/袋),纳他霉素检出值为7.4mg/kg,标准规定不得使用。检验机构为广西-东盟食品药品安全检验检测中心。
(十三)三江县永利批发部销售的标称“罗城仫佬族自治县博城食品厂”生产的“切馅饼”样品(商标:/,生产日期/批号:2018-06-09,规格:300克/袋),脱氢乙酸及其钠盐(以脱氢乙酸计)检出值为0.92g/kg,标准规定检出值为≤0.5g/kg。检验机构为广西-东盟食品药品安全检验检测中心。
(十四)都安吉兴副食品批发部销售的标称“南宁市武鸣县冠香食品厂”生产的“绿豆面包”样品(商标:冠香煌及图形商标,生产日期/批号:2018-08-09,规格:90克/袋),脱氢乙酸及其钠盐(以脱氢乙酸计)检出值为0.66g/kg,标准规定检出值为≤0.5g/kg;标称“南宁市武鸣县冠香食品厂”生产的“冠香牛奶堡”样品(商标:冠香煌及图形商标,生产日期/批号:2018-08-09,规格:90克/袋),脱氢乙酸及其钠盐(以脱氢乙酸计)检出值为0.66g/kg,标准规定检出值为≤0.5g/kg。检验机构为广西-东盟食品药品安全检验检测中心。
(十五)柳城县太平镇佳家用超市销售的标称“西咸新区康利园食品有限公司”生产的“慕斯蛋糕”样品(商标:麦尚吧,生产日期/批号:2018-07-01,规格:散装称重),防腐剂混合使用时各自用量占其最大使用量的比例之和为1.4,标准规定检出值为≤1。检验机构为广西-东盟食品药品安全检验检测中心。
三、不合格食品查处情况
对上述抽检中发现的不合格食品,各相关市、县(市、区)食品药品监管部门均已依法进行处置。
科普小课堂

菌落总数
菌落总数是指示性微生物指标,并非致病菌指标。主要用来评价食品清洁度,反映食品在生产过程中是否符合卫生要求。
本次监督抽检发现 1 批次饮料(葛根粉)存在菌落总数超标的情况,说明个别企业可能未按要求严格控制生产加工过程的卫生条件,或者包装容器清洗消毒不到位,还有可能与产品包装密封不严、储运条件控制不当等有关。
铜绿假单胞菌
铜绿假单胞菌是一种条件致病菌,广泛分布于各种水、空气、正常人的皮肤、呼吸道和肠道等,易在潮湿的环境存活,对消毒剂、紫外线等具有较强的抵抗力,对于抵抗力较弱的人群存在健康风险。

本次监督抽检发现有 4 批次瓶装饮用水存在铜绿假单胞菌超标的情况。天然矿泉水中铜绿假单胞菌超标可能是源水防护不当,水体受到污染;生产过程中卫生控制不严格,如从业人员未经消毒的手直接与矿泉水或容器内壁接触;或者是包装材料清洗消毒有缺陷所致。
脱氢乙酸及其钠盐
脱氢乙酸是具有防腐作用的食品添加剂,根据食品安全国家标准和相关产品标准的规定,不允许超范围或超限量使用添加剂。

本次监督抽检发现 3 批次糕点样品存在超限量使用脱氢乙酸和 1 批次粮食加工品样品存在超范围使用脱氢乙酸的情况,原因可能是企业为了增加产品保质期,或者弥补产品生产过程卫生条件不佳而超范围或超限量使用。
铅
铅属于重金属污染物指标。铅对人体的危害主要是慢性蓄积性,长期大量摄入铅含量超标的食品可能导致神经系统、泌尿系统等损伤风险。《食品安全国家标准 食品中污染物限量》(GB2762-2017)规定固体饮料铅含量≤1.0mg/kg。

本次监督抽检发现有 2 批次固体饮料存在铅超标的情况,超标的原因可能是使用了铅含量超标的原料,也不排除从生产设备迁移入食品的可能。
小编提醒,
如果您在生活中遇到食品、药品、
保健食品、化妆品和医疗器械相关问题,
请及时拨打12331进行投诉举报。
来源│广西食药监管
编辑│南音
编审│陈健声
贺州人民广播电台
微观天下,广播贺州
